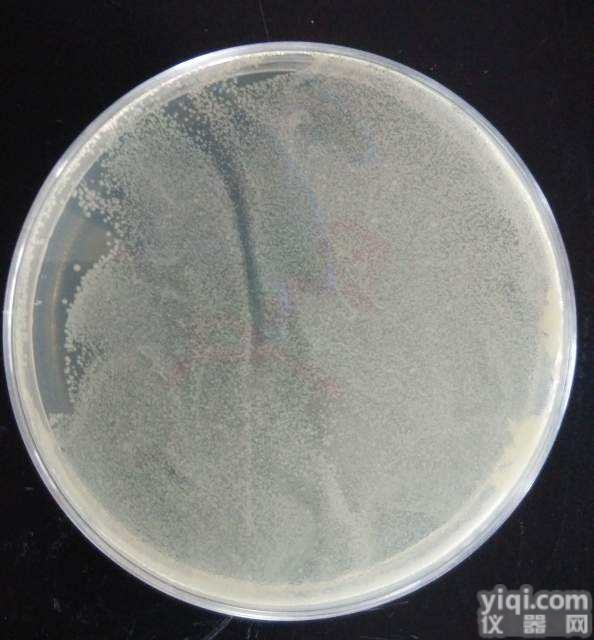
EHA105  电<em>转化</em><em>感受</em>态<em>细胞</em>

EHA105 电转化感受态细胞
- 品牌:cmbio
- 供应商:上海淳麦生物科技有限公司
- 供应商报价:面议
- 标签:EHA105 电转化感受态细胞,-1,上海淳麦生物科技有限公司
| 品牌 | 自营品牌 | 供货周期 | 现货 |
|---|
| 货号: | CM-6059G |
| 供应商: | 上海淳麦 |
| 数量: | 1000只 |
| 英文名: | JM110Chemically Competent Cell |
| 保质期: | 1年 |
| 保存条件: | 零下80度 |
| 规格: | 20*100ul |

EHA105 Electroporation-Competent Cell
产品编码: 保存条件: -80℃
产品规格:
| EHA105 | 20×50μl |
| pCAMBIA2301(control vector) | 10ng/ul 10ul |
EHA105农杆菌电转感受态细胞基因型;
C58 (rif R) Ti pEHA105 (pTiBo542DT-DNA) (strepR) Succinamopine
EHA105农杆菌电转感受态细胞简要说明:
EHA105菌株由EHA101菌株改造而来,为C58型背景,核基因中含有筛选标签——利福平抗性基因rif,为了便于转化操作,此菌株携带一无自身转运功能的琥珀碱型Ti质粒pEHA105 (pTiBo542DT-DNA) ,此质粒含有vir基因(vir基因是T-DNA插入植物基因组必需的元件,pEHA105 (pTiBo542DT-DNA)质粒自身的T-DNA转移功能被破坏,但可以帮助转入的双元载体T-DNA顺利转移)。
pEHA105 (pTiBo542DT-DNA)型Ti质粒含有筛选标签:strep,赋予EHA105菌株链霉素抗性,适用于水稻、烟草等植物的转基因操作。
开发的EHA105电转感受态特别适用于大质粒的转化:经pCAMBIA2301质粒(size:11633bp)检测转化效率可达5×104cfu/μg;经pCAMBIA2301-ZH质粒(size:40kd)检测转化效率可达5×103cfu/μg。
EHA105农杆菌电转感受态细胞操作说明:
1. 0.2cm 电击杯和杯盖从储存液中拿出倒置于干净的吸水纸上5分钟,待其沥干水分,正置5分钟,使乙醇充分挥发,待乙醇挥发干净立即插入冰中,压实冰面,电极杯顶离冰面0.5cm以方便盖上杯盖,冰中静置5分钟充分降温。